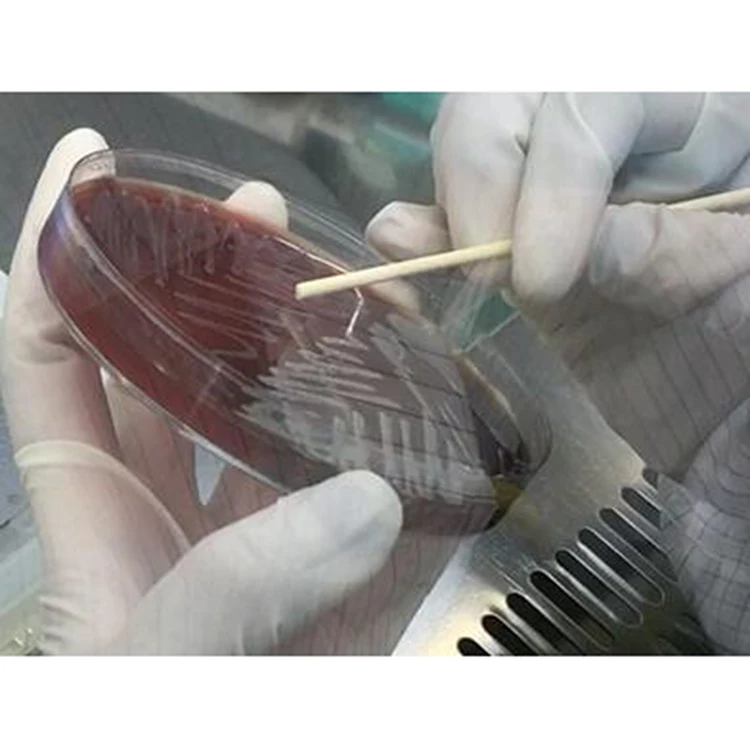
China Laboratory Equipment Automatic High Reliability Mass Spectrometer System

China Laboratory Equipment Automatic High Reliability Mass Spectrometer System
- Category: >>>
- Supplier: Zhuhai Meihua Medical Technology Co. Ltd.
Share on (1600475779171):
Product Overview
Description
Products Description

Product name | mass spectrometry | ||||||
Warranty | 2 year | ||||||
Mass range | 1~300KDa | ||||||
Mass resolution | >2000; (4-HCCA, [M3+H]+,568 Da) | ||||||
Sensitivity | 1fmol/uL S/N>50:1 (Insulin) | ||||||
Quality accuracy | <30ppm | ||||||
Quality stability | <500ppm/8h | ||||||
Packing Measurement | 75x80x140CM | ||||||
G.W. | 150KGS | ||||||
Product show

Related Products

Company Profile


Transport Logistics


FAQ

Q: How to purchase your products ?
A: Please inform us your detailed requirement or demand, we will offer some recommendation. After your confirmation, we will issue a formal proforma invoice (PI) for your final confirmation and payment. You can purchase from us directly or via Alibaba Trade Assurance Order.
Q: What's the warranty for the products ?
A: The standard warranty is one year from the date of arrival. In addition, we will still provide good after-sales service after warranty period.
Q: What kind of after-sales service include?
A: Online Technical Support, other remote technical support; Spare part support, Training, Field Service if requested
Q: Can we visit your factory ?
A: Of course, welcome to visit our factory if you come to China.
Q: What's the production date after we confirm the order ?
A: This depends on the quantity and specific requirement. Normally, for the mass production, we need about 35-40 days to finish the production. For some regular reagents, we can provide within 7 days after the confirmation.
Q: Is OEM or ODM service available
A: Available upon request.
A: Please inform us your detailed requirement or demand, we will offer some recommendation. After your confirmation, we will issue a formal proforma invoice (PI) for your final confirmation and payment. You can purchase from us directly or via Alibaba Trade Assurance Order.
Q: What's the warranty for the products ?
A: The standard warranty is one year from the date of arrival. In addition, we will still provide good after-sales service after warranty period.
Q: What kind of after-sales service include?
A: Online Technical Support, other remote technical support; Spare part support, Training, Field Service if requested
Q: Can we visit your factory ?
A: Of course, welcome to visit our factory if you come to China.
Q: What's the production date after we confirm the order ?
A: This depends on the quantity and specific requirement. Normally, for the mass production, we need about 35-40 days to finish the production. For some regular reagents, we can provide within 7 days after the confirmation.
Q: Is OEM or ODM service available
A: Available upon request.
We Recommend
New Arrivals
New products from manufacturers at wholesale prices